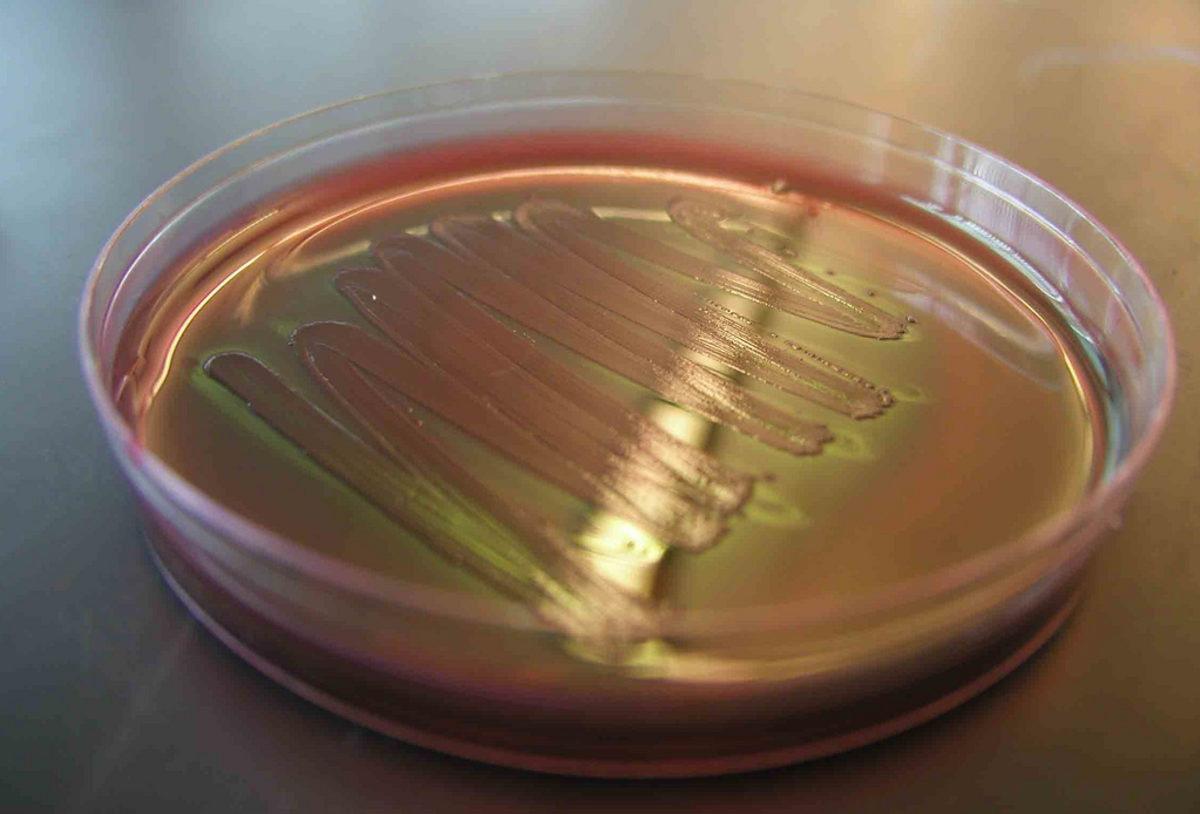
En Derin Okyanus Çukurunda Petrol Yiyen Bakteri Bulundu

Dünyanın en derin çukuru olarak da bilinen Mariana Çukuru, bilim insanlarının ve araştırmacıların büyük ilgisini çekiyor. Dünyanın en yüksek dağı olan Everest’in yüksekliği 8.848 metre iken Mariana’nın derinliği yaklaşık 11.000 metre.
Araştırmayı yöneten isimlerden Prof. Xiao-Hua Zhang, “Mars hakkında okyanusların en derin yerleri hakkında bildiğimizden daha fazla şey biliyoruz.” diyor.
Bugüne kadar Mariana çukurunu inceleyen pek çok farklı araştırmacı oldu. Bunlardan biri Oscar ödüllü yönetmen James Cameron’du. O kadar büyük ilgi gören Mariana hakkında yeni bilgiler edinmeye başladık.
UEA Biyolojik Bilimler Okulu’ndan Dr. Jonathan Todd, Mariana Çukuru’ndan mikroorganizma örnekleri topladıklarını, bu örnekleri gruplandırdıklarını ve hidrokarbon indirgeyen yeni bir grup bakteri keşfettiklerini söyledi.
Hidrokarbonların sadece hidrojen ve karbon atomlarından oluştuğunu söyleyen bilim insanı, bu tür yapıların ham petrol ve doğal gazlarda da bulunduğunu söyledi. Bu mikroorganizmaların petrol gibi maddeleri yiyerek yaşadıklarını belirten Todd, 2010 yılında BP’nin Meksika Körfezi’nde bir felakete yol açan petrol sızıntısında da bu tür bakterilerin denizleri temizlemekte kullanıldığını hatırlattı. Araştırmacı, bu bakteri türlerinin Mariana Çukuru'nda oldukça bol miktarda bulunduğunu belirtti.

Araştırmacılar, normalde yüzeyde kirlilik nedeniyle bu tür yapıların ortaya çıktığını ancak bu derinliklerde de özel koşullardan kaynaklı olarak hidrokarbon bakterilerin ortaya çıktığını söylüyorlar. Bilim insanlarına göre bu bakteriler, aynı zamanda bölgedeki mikroplar ve daha büyük organizmalar için de besin görevi görüyor. 6 kilometre derinlikte alınan örneklerde bol miktarda bulunan bakterilerin daha derinlerde de yaşadığına kesin gözüyle bakılıyor.


